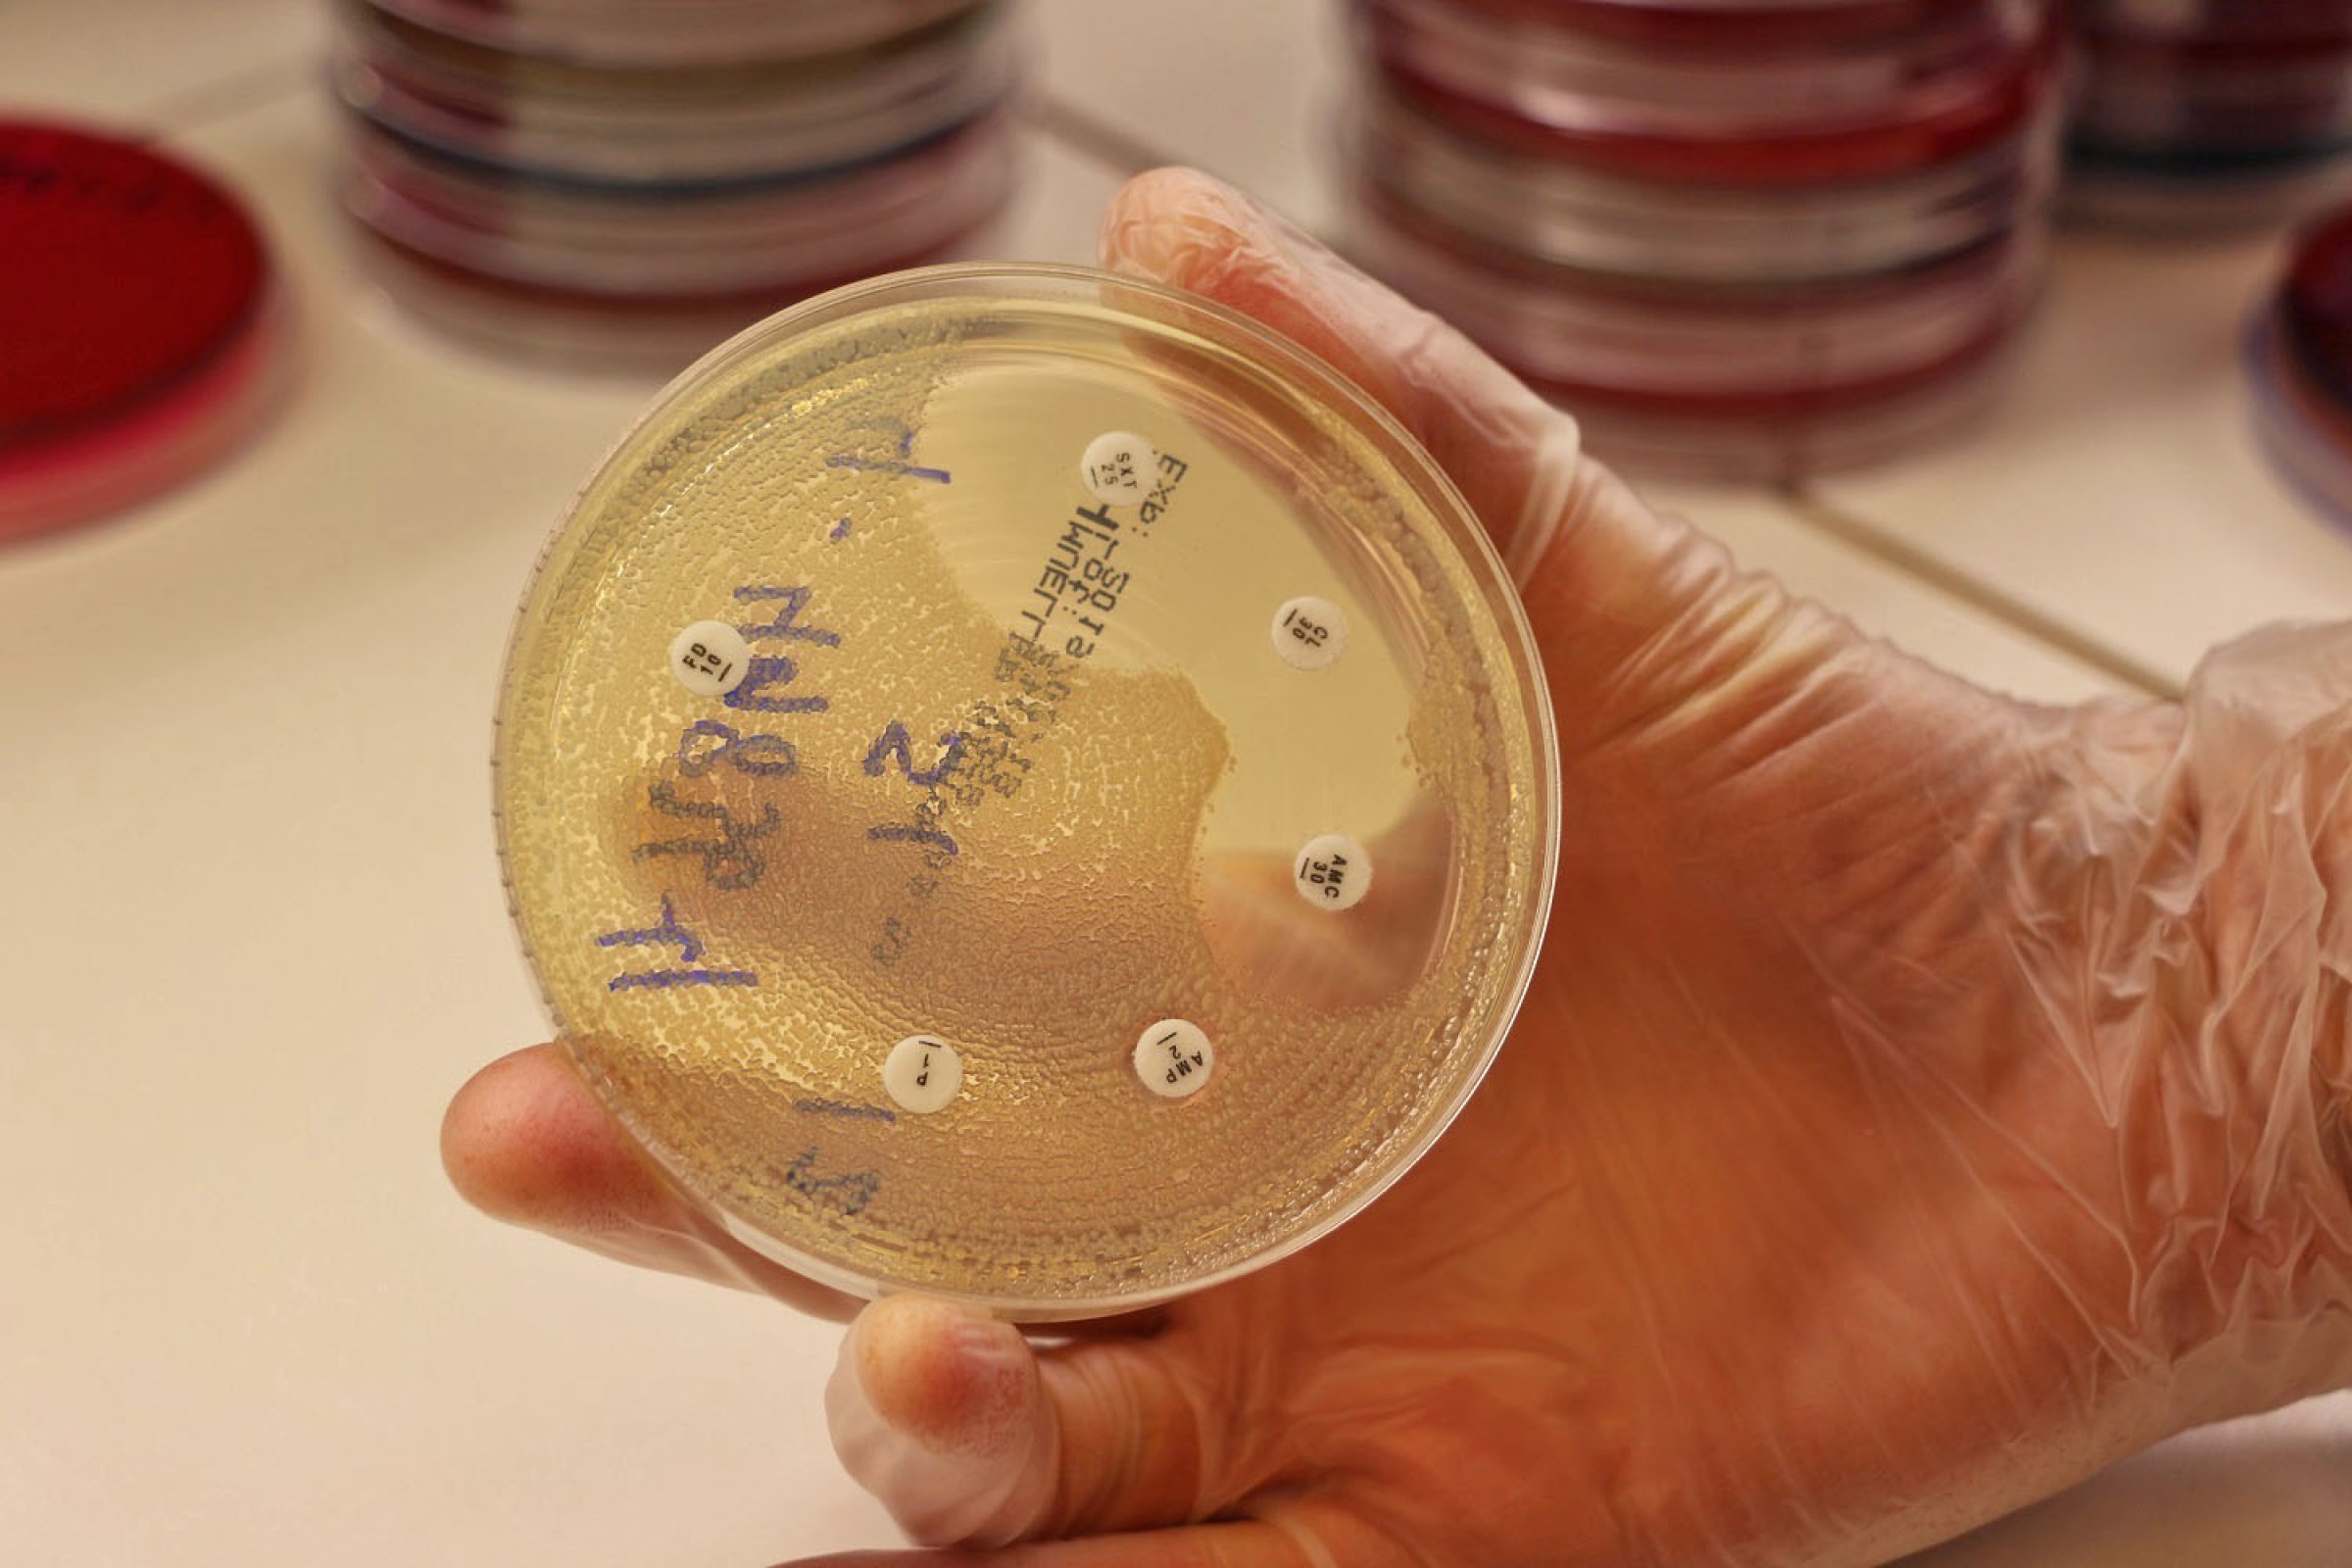

Resistenstester alle prøver med sykdomsfremkallende bakterier
Denne uken markeres World Antibiotic Awereness Week og European Antibiotic Awareness Day 18. november. Årlig resistenstester Veterinærinstituttet tusenvis av bakterier fra prøver innsendt av veterinærer.
– At veterinærer sender inn prøver for å finne ut hva som er årsak til sykdom er viktig for å hindre unødvendig bruk av antibiotika, og også for at de skal kunne skrive ut riktig type antibiotika. Det har blitt større bevissthet omkring restriktiv antibiotikabehandling blant veterinærer og på veterinær-studiet, og det er bra, sier forsker Marianne Gilhuus ved Veterinærinstituttet.
Resistenstesting som standard
Veterinærinstituttet resistenstester alltid når det påvises sykdomsfremkallende bakterier i en prøve. Men før man kommer så langt går innsendte prøver gjennom de samme rutinene med dyrking på vekstmedier ved 37°C over natt. Er det ingen bakterievekst påfølgende dag dyrkes de et ekstra døgn.
Ofte er det som vokser fram bakterier som er lett gjenkjennelige for et trent øye. Det kan være stafylokokker, E. coli eller streptokokker. Andre ganger dukker det opp mer ukjente bakterier eller unormal vekst. Ofte er det også blandet bakterievekst i skålene. Da må man klare å skille bakteriene fra hverandre slik at man får renkultur av en bakterien før man kan sjekke om bakterien er følsom eller resistent for antibiotika.
Tabletter på skål
Veterinærinstituttet tester mot de antibiotikatypene veterinærer i Norge vanligvis skriver ut. Ved resistenstesting av bakterier fra syke dyr benyttes en såkalt lappediffusjonstest, der vekst av bakterien omkring lapper (tabletter) med antibiotika angir om den er følsom eller resistent mot antibiotikatypen i de ulike lappene. Diameteren uten bakterievekst omkring en antibiotika-lapp måles for å avgjøre om bakterien er følsom eller resistent mot den aktuelle antibiotikaen. Denne sonegrensen er ulik fra bakterietype til bakterietype, og er årsaken til at bakterien må identifiseres og være i renkultur før den kan resistenstestes.
For noen type bakterier er det kjente resistensformer det alltid sjekkes for. Stafylokokker testes f.eks. alltid for om de kan være i gruppen Meticillinresistente stafylokokker (forkortet MRSA og MRSP), og enterobakterier sjekkes om de er resistente mot 3. generasjons cefalosporiner (kjent som ESBL-produserende bakterier). Dette er resistensformer vi har spesiell fokus på, da de ofte er multiresistente og dermed vanskelig å behandle. Ved sterk mistanke blir det gjort videre genetiske undersøkelser.
Resistenstesting tar ett døgn. Normalt tar det 2-3 arbeidsdager fra mottatt prøve til svar foreligger. Gilhuus understreker at veterinærer bør vurdere prøveresultat og eventuell resistens sammen med kliniske funn. Resultat av resistenstesting er kun ment som en veiledning når det gjelder behandling. For generelle råd henvises til Statens legemiddelverk.
Prøvetaking og innsending
– De fleste veterinærer er veldig nøyaktige og tar ut og sender inn prøver slik vi ønsker å få dem tilsendt. Vi mottar også noen prøver som ikke er godt egnet til analyse. Dette gjelder for eksempel avføring innsendt i vrengte gummihansker. Det er lite praktisk å jobbe med på laboratoriet og øker sjansen for å spre smitte, sier Gilhuus.
Hun anbefaler veterinærer som er i tvil om hvordan prøvene skal sendes inn å ringe laboratoriet for råd.
Prøver skal tas med standardisert teknikk for å hindre forurensing. For de fleste formål er det greit å ta prøve med bomullspinne/svaber som settes på standard transportmedium. Større prøvemengder (f.eks. avføring) sendes i støtsikkert plastbeger med skrulokk, og væsker kan sendes på blodprøveglass uten tilsetning. Tydelig merking er viktig. Prøvene bør oppbevares kjølig og frostfritt fram til innsending.